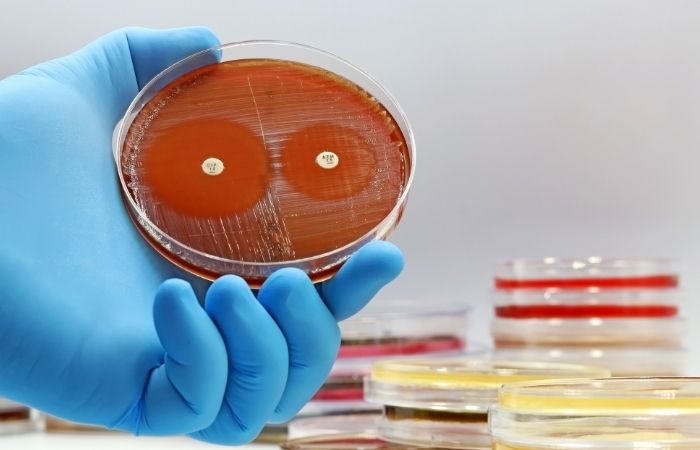

Can I Test for an STD While on Antibiotics? Here’s the Truth
Quick Answer: Super gonorrhea is a drug-resistant form of Neisseria gonorrhoeae that no longer responds to standard antibiotic treatments. It spreads the same way as regular gonorrhea, through unprotected vaginal, oral, or anal sex, but it’s much harder to treat. You’re at risk if you’ve had recent unprotected sex, especially with new or multiple partners, and haven’t been tested. Early testing is critical, especially if symptoms are present, or if you're asymptomatic but sexually active.
What Exactly Is Super Gonorrhea?
“Super gonorrhea” isn’t a different disease, it’s just regular gonorrhea, upgraded with drug resistance. Thanks to decades of antibiotic overuse and under-treatment, this bacteria has mutated into a version that can dodge the meds we used to rely on.
The scary part? There are now gonorrhea strains resistant to nearly every class of antibiotics, including:
- Azithromycin
- Ceftriaxone
- Doxycycline
- Ciprofloxacin
In some regions, Thailand, the U.K., Australia, and parts of the U.S., we’re seeing “extensively drug-resistant” gonorrhea (XDR-GC), where none of the go-to meds work. Treatment becomes experimental. And outcomes? Less predictable.
This is no longer a distant risk. In 2023, the U.S. confirmed its first cases of gonorrhea resistant to both azithromycin and ceftriaxone, the last combo standing. Those patients recovered, but the warning is clear: we’re running out of options.
People are also reading: We Both Tested Positive, Now What?
How Does It Spread?
Same as always. Super gonorrhea doesn’t need new rules, it plays by the old ones, just better:
- Unprotected vaginal sex
- Unprotected anal sex
- Unprotected oral sex (yes, throat gonorrhea is real, and harder to treat)
- Sharing sex toys without proper cleaning or condoms
It’s highly contagious. You can get it from a single encounter. And it can infect the genitals, rectum, throat, and even eyes in rare cases. Transmission doesn’t require ejaculation, just exposure to infected fluids or mucous membranes.
And here's the twist: you don’t need to feel sick to be contagious. In fact, a majority of people, especially those with throat or rectal infections, have zero symptoms. That’s how super strains travel undetected.
Symptoms of Super Gonorrhea: Are They Different?
Nope. Super gonorrhea looks and feels just like the regular version, at first. The difference is what happens after you start treatment. With drug-resistant strains, symptoms may persist, worsen, or return after a few days. That’s a red flag.
Figure 1. Common symptoms of gonorrhea across different body sites. Super gonorrhea shows the same signs, but may not go away with standard treatment.
If you’ve been treated for gonorrhea recently and your symptoms haven’t improved in 3–5 days, that’s your cue. Get re-tested. Let your provider know resistance is a concern. Don’t assume treatment worked, super strains don’t play by the rules.
Why Is Super Gonorrhea Becoming a Thing?
One word: resistance. Gonorrhea has a PhD in survival. Over the past few decades, it’s steadily adapted to each new class of antibiotics we’ve thrown at it. Every time treatment is incomplete, missed doses, wrong drugs, poor access, gonorrhea learns. And evolves.
It’s like natural selection in fast-forward. The weak bacteria die off. The stronger ones? They multiply. Eventually, the only strains left are the ones that laugh in the face of your prescription.
The CDC once had a playbook of seven drugs for gonorrhea. We’re now down to a single injectable, ceftriaxone, and even that’s slipping. Resistance is already documented in more than 50 countries. Some strains are now resistant to three or more antibiotics at once.
Super gonorrhea isn’t some future horror. It’s here. It's just not everywhere... yet.
The Hidden Engine: Throat Infections
Let’s talk about pharyngeal gonorrhea, the throat version. It’s the sleeper agent of the STD world. Why?
- It rarely causes symptoms
- It often goes undiagnosed
- It's harder to treat than genital infections
The back of the throat is where gonorrhea gets really smart. It’s exposed to small, non-lethal doses of antibiotics, like the leftovers from treating other infections (strep, sinusitis, etc.). Those low doses don’t kill the bacteria. They just teach it how to fight back.
Then, when someone goes down on a partner, or gets oral without protection, they pass the resistant strain like a handshake.
Super gonorrhea is a throat-based Trojan horse. It spreads through oral sex, masks itself in silence, and creates harder-to-treat infections that don’t show up in regular STI tests unless you specifically swab the throat.
Who’s Most at Risk?
People who are sexually active but not consistently protected and tested. Yet certain groups are more at-risk because of their level of exposure, social stigmas, and differences in access to care:
- People with multiple or anonymous partners
- Men Who Have Sex with Men (MSM), especially those occurring in metropolitan regions with known resistant strains
- People having unprotected sex - both anal and/or oral
- People with a history of untreated or recurrent STIs
It’s more than behavior, though; it’s about testing. People tend to think that if they feel okay, they are okay. That’s how this virus is transmitted, quietly, steadily, and unseen.
And let’s be clear: if you’ve ever had unprotected oral sex, you could be a carrier without knowing it.
Why Super Gonorrhea Is So Dangerous
It’s not just an inconvenience, it’s a ticking time bomb. Left untreated (or mistreated), gonorrhea can cause:
- Pelvic Inflammatory Disease (PID) in people with vaginas, leading to infertility, ectopic pregnancy, chronic pain
- Epididymitis in people with penises, pain, swelling, and potential sterility
- Disseminated gonococcal infection (DGI) , a rare, serious spread to blood, joints, or brain
In other words: this isn’t just about a sore throat or funky discharge. Super gonorrhea can cripple your reproductive health, increase HIV transmission risk, and in rare cases, kill you.
The stakes are real. The risks are rising. And the only real defense left? Testing early. Testing often.
Super Gonorrhea in the Real World: Yes, It’s Already Here
This is no hype. Super-gonorrhea is already present in the U.S., U.K., Japan, and other parts of Southeast Asia. This isn’t about theory—it is about actual patients and actual resistance.
As per 2023 reports by the CDC, there were two instances recorded within Massachusetts where there was resistance to five different classes of antibiotics. Additionally, one of these resistance cases did not involve travel to other parts of the country, which indicated resistance within their environment. Despite this, both cases managed to recover due to personalized care.
Globally, the situation’s even more sobering. In the U.K., a tourist brought back a strain from Southeast Asia that was resistant to nearly all antibiotics. It didn’t respond to first-line or second-line treatments. Doctors had to dig deep into the pharmaceutical toolbox to find anything that worked.
This isn’t just about individual cases, it’s about a systemic shift. We are entering the post-antibiotic era for some STDs, and gonorrhea is leading the charge.

People are also reading: Scared to Have Sex Again After an STD? Here’s the Real Talk You Need
How Do Health Officials Track It?
When a resistant case is suspected, here’s what typically happens behind the scenes:
- The provider sends a sample for gonorrhea culture and antibiotic susceptibility testing
- Positive results are mandatorily reported to local health departments
- If resistance is detected, it’s flagged to the CDC’s Gonococcal Isolate Surveillance Project (GISP)
- Public health teams may launch partner tracing to contain further spread
This system helps scientists identify emerging resistance trends, and keeps the treatment guidelines one step ahead. But here's the truth: testing and contact tracing are only as effective as the number of people actually getting tested. If most people skip screening, the data becomes a guessing game.
That’s why personal testing matters more than ever. You’re not just protecting yourself, you’re contributing to surveillance that could stop an outbreak in your city before it snowballs.
Why Testing Now Can Protect Your Future Fertility
Here’s what a lot of people don’t realize: gonorrhea doesn’t just infect you and disappear. Left untreated, it can scar your reproductive organs permanently.
For people with vaginas, gonorrhea can lead to Pelvic Inflammatory Disease (PID). It’s one of the top causes of infertility, and it often shows up quietly. No big symptoms, just slow internal damage until the fallopian tubes are too scarred for eggs to travel.
For people with penises, it can cause epididymitis, a painful inflammation of the tube that stores and carries sperm. Chronic infections can lead to reduced sperm count or even sterility.
And if the infection spreads to the bloodstream (a rare but real complication), it can affect your joints, heart, or brain. This isn’t just a “get a shot and forget it” infection anymore.
When “One Time” Was Enough
“Chris (32) had unprotected oral sex with a new partner while traveling. No big deal, right? A week later, he had a sore throat, but chalked it up to dry air. He didn’t get tested until weeks later, when symptoms returned after treatment. Turns out, he had a resistant gonorrhea strain hiding in his throat. It took multiple rounds of meds and specialist visits to finally clear it.”
Chris’s story isn’t unique. Throat infections are one of the easiest ways to unknowingly carry and spread super gonorrhea. The worst part? Most standard STD panels don’t include throat swabs unless you specifically ask.
So if you’ve ever thought, “It was just oral, it doesn’t count,” consider this your wake-up call.
The Bottom Line
Super gonorrhea isn’t just a buzzword, it’s a growing global threat. But it’s not unbeatable. With proper protection, consistent testing (especially at multiple body sites), and fast treatment follow-ups, we can keep this from turning into the next public health crisis.
Still unsure where you stand? A discreet, combo STD test kit can screen for gonorrhea (and more) from the privacy of home. No clinics. No waiting rooms. Just clarity, on your terms.
FAQs
1. Can I really get gonorrhea just from oral sex?
Yes, and it’s one of the main reasons super gonorrhea is thriving. Oral sex often gets a free pass in people’s minds, no condom, no worries, but the throat is actually one of gonorrhea’s favorite hiding spots. No symptoms, no suspicion, and boom, transmission. If you’ve been skipping condoms during oral, it’s worth getting a throat swab with your next test. Most people don’t, and that’s how it spreads.
2. My symptoms came back after treatment. Is that normal?
It can happen, but it’s not good news. If symptoms linger or return, your gonorrhea might be resistant to the meds you took. Don’t guess, and definitely don’t “borrow” old antibiotics. Head back to a clinic and ask for a culture test. Super strains play dirty. You need a confirmed game plan, not a DIY remedy.
3. How do I even know if I have super gonorrhea?
You won’t know just from symptoms. Super gonorrhea looks exactly like the regular kind, it just refuses to die when treated. The only way to confirm it is through a culture test, which checks what antibiotics still work. But that starts with a standard STD test. So if you’re sexually active and haven’t screened recently? That’s your move.
4. Are condoms enough to stop it?
They’re your best bet. Are they perfect? No. But they block the majority of transmission routes. Especially if you’re using them for oral and anal sex, which most people skip. If you want a real-world shield against super gonorrhea, condoms + regular testing = the combo that works.
5. Does this mean we’re heading into an STD apocalypse?
Not if we get ahead of it. Gonorrhea is fast, but so is science. The real problem isn’t medicine, it’s that people don’t test, don’t finish treatment, or don’t know they’re even infected. Super gonorrhea wins when we stay quiet. But if more people screen early and treat fully, we cut off its power. No apocalypse necessary.
6. Can I get tested for this at home?
Yes, for gonorrhea, absolutely. Many home STD kits cover gonorrhea in multiple sites (urine, vaginal, rectal). What they can’t do is tell you if the strain is drug-resistant. That takes a lab culture. But you’ve gotta test first to even know if you're positive. So yes, start at home if that feels safer or more doable, just don’t stop there if treatment doesn’t work.
7. If I’ve had gonorrhea before, am I more likely to get it again?
Unfortunately, yes. There’s no immunity after infection. In fact, repeat gonorrhea is incredibly common, especially if partners weren’t treated or follow-up testing didn’t happen. Think of it like a reset button. Every new exposure = new risk.
8. How soon after treatment should I get retested?
For gonorrhea, you should retest 2–3 weeks after finishing antibiotics to make sure it’s gone, especially if symptoms were intense or you’re in a high-risk group. Don’t wait months to find out it didn’t clear. Retesting is the final step, not a bonus round.
9. I’m embarrassed to tell my partner. Should I?
It sucks. But yes, you have to. Super gonorrhea can affect their health too, and if they’re untreated, you’ll just pass it back and forth. You don’t need a TED Talk, just honesty. Try: “I tested positive and I want us both to be safe. You should get tested too.” Short. Real. Respectful.
10. Do people die from this?
It’s rare, but possible. Untreated gonorrhea (especially drug-resistant strains) can spread to your joints, blood, or brain. That’s called DGI (disseminated gonococcal infection) and it’s no joke. You’re unlikely to die if you test and treat early. But if you ignore it? The risks escalate fast.
Your Next Move: Test Smart, Stay Ahead
Super gonorrhea doesn’t care how “clean” you feel. It doesn’t care if you only had oral. It doesn’t even care if you already got treated last month. It spreads silently, hides deep, and adapts fast. But here’s the part it can’t outrun: you getting tested early.
Be the reason it stops. Whether that’s with a discreet home combo test, a full clinic screen, or a retest after treatment, you’re not just protecting yourself, you’re helping put a wall between this superbug and everyone else.
How We Sourced This Article: We drew on clinical guidelines from the CDC, real-time resistance data from the WHO, peer-reviewed studies on pharyngeal gonorrhea, and firsthand reports from sexual health practitioners seeing these cases in urban clinics. Around fifteen reputable sources were used to build this article; below, we’ve highlighted some of the most relevant and reader-friendly sources.
Sources
1. Multi-drug resistant gonorrhoea | WHO
2. Drug-Resistant Gonorrhea – CDC
3. Gonococcal Infections Among Adolescents and Adults – STI Treatment Guidelines | CDC
4. “Super Gonorrhea”: Causes, Testing & Treatment | Medical News Today
5. “Super Gonorrhea” Is Evolving as a Greater Treatment Challenge | ContagionLive
About the Author
Dr. F. David, MD is a board-certified infectious disease physician specializing in STDs, antibiotic resistance, and discreet patient-first care. He’s spent over a decade helping people navigate complex diagnoses with clarity and compassion.
Reviewed by: Emily R. Vance, RN, MPH | Last medically reviewed: November 2025
This article is for informational purposes only and is not a substitute for professional medical advice, diagnosis, or treatment.






